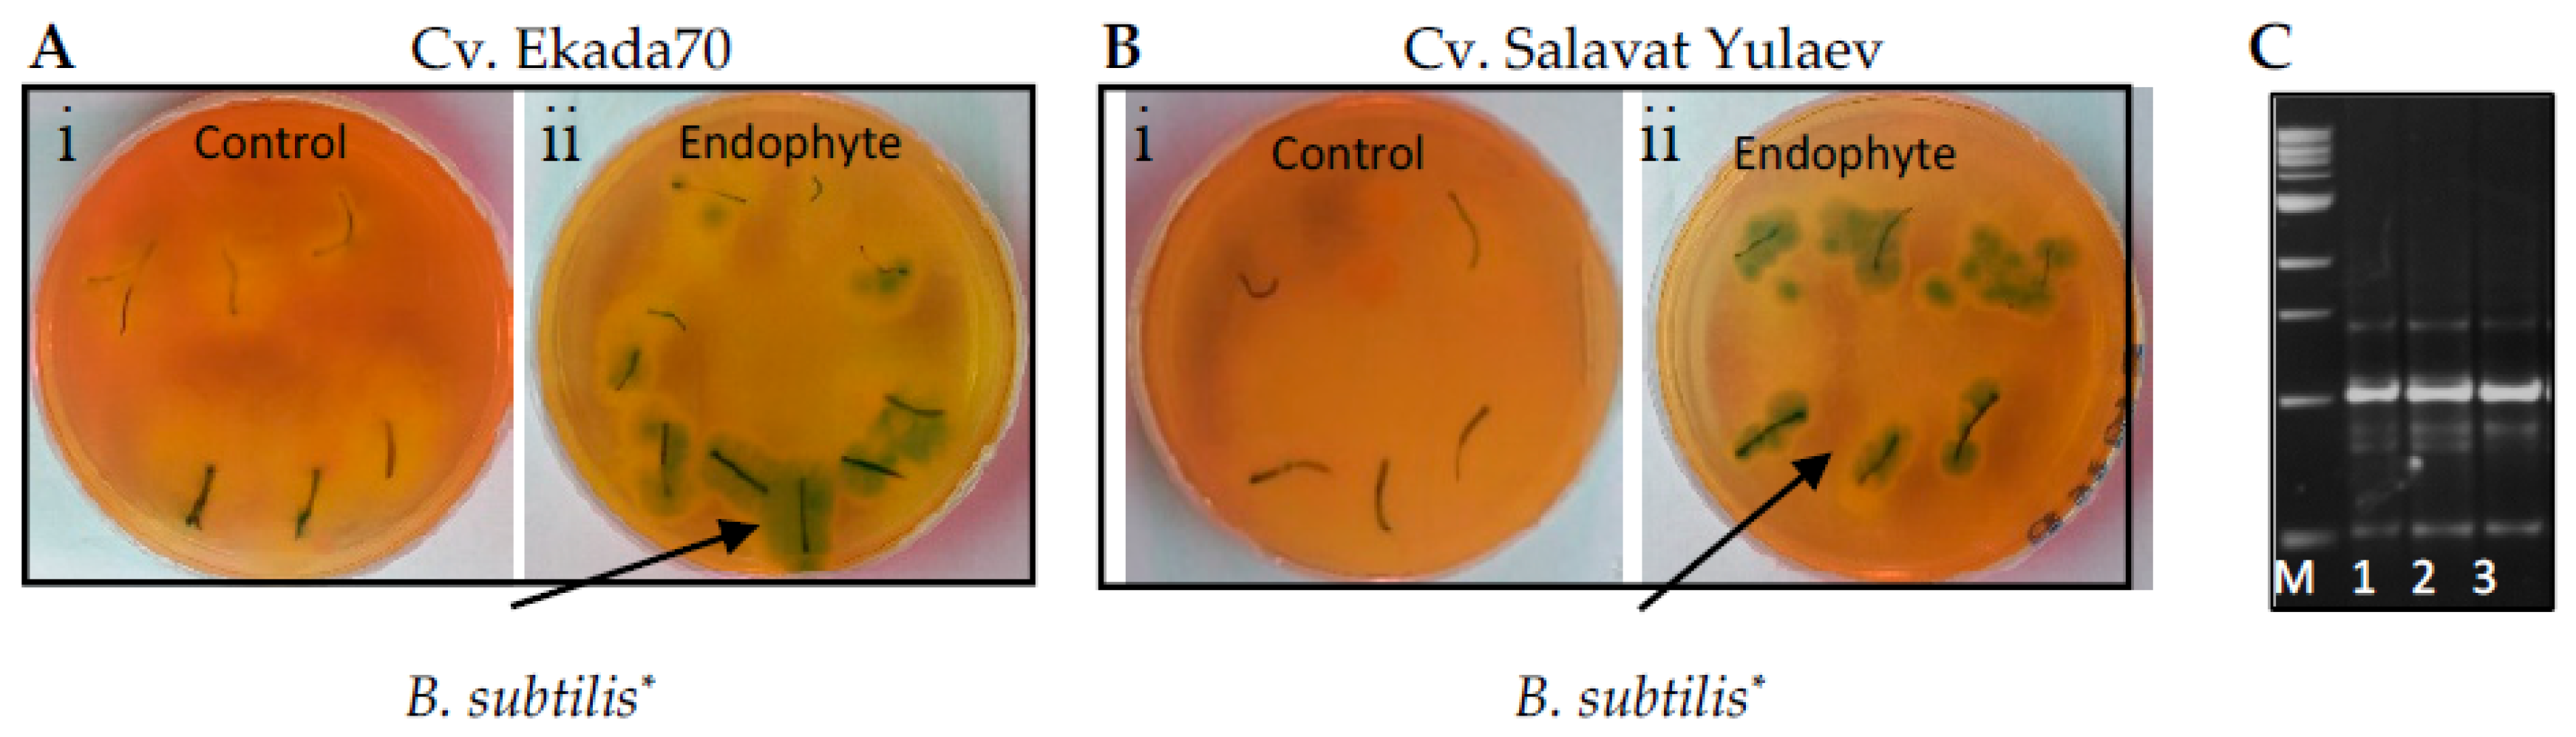
Plants 09 01810 g001 Plants 09 01810 g001

Seed Priming with Endophytic Bacillus subtilis Modulates Physiological Responses of Two Different Triticum aestivum L. Cultivars under Drought Stress
Abstract
1. Introduction
2. Materials and Methods
2.1. Bacterial Strain and Inoculum Preparation
2.2. Plant Materials, Growth Conditions, and Growth Parameters Assay
2.3. Seed Germination Assay
2.4. Seedlings Colonization Assay
2.5. Determination of Photosynthetic Pigments
2.6. Determination of Water Holding Capacity (WHC) of Leaves
2.7. Assessments of Proline (Pro), Electrolyte Leakage (EL), and Lipid Peroxidation (MDA)
2.8. Endogenous Salicylic Acid (SA) Extraction and Quantification
2.9. Statistical Analysis
3. Results
3.1. Seedling Colonization with Bacillus subtilis 10-4
3.2. Germination
3.3. Seedling Growth
3.4. Photosynthetic Pigments
3.5. Water Holding Capacity (WHC)
3.6. Electrolyte Leakage and Lipid Peroxidation
3.7. Proline (Pro)
3.8. Endogenous Salicylic Acid (SA)
4. Discussion
5. Conclusions
Author Contributions
Funding
Acknowledgments
Conflicts of Interest
References
- Lastochkina, O.; Aliniaeifard, S.; Kalhor, M.S.; Yuldashev, R.; Pusenkova, L.; Garipova, S. Plant Growth Promoting Bacteria—Biotic Strategy to Cope with Abiotic Stresses in Wheat. In Wheat Production in Changing Environments: Management, Adaptation and Tolerance; Hasanuzzaman, M., Nahar, K., Hossain, A., Eds.; Springer Nature: Singapore, 2019; Chapter 23; pp. 579–614. [Google Scholar]
- Kosova, A.; Varma, A.; Choudhary, D.K. Pseudomonas-mediated mitigation of salt stress and growth promotion in Glycine max. Agric. Res. 2015, 4, 31–41. [Google Scholar]
- Khan, M.Y.; Zahir, Z.A.; Asghar, H.N.; Waraich, E.A. Preliminary investigations on selection of synergistic halotolerant plant growth promoting rhizobacteria for inducing salinity tolerance in wheat. Pak. J. Bot. 2017, 49, 1541–1551. [Google Scholar]
- Sun, Y.; Wang, C.; Chen, H.Y.H.; Ruan, H. Response of Plants to Water Stress: A Meta-Analysis. Front. Plant Sci. 2020, 11, 978. [Google Scholar] [CrossRef] [PubMed]
- Sallam, A.; Alqudah, A.M.; Dawood, M.F.; Baenziger, P.S.; Börner, A. Drought Stress Tolerance in Wheat and Barley: Advances in Physiology, Breeding and Genetics Research. Int. J. Mol. Sci. 2019, 20, 3137. [Google Scholar] [CrossRef] [PubMed]
- Lutts, S.; Benincasa, P.; Wojtyla, Ł.; Kubala, S.; Pace, R.; Lechowska, K.; Quinet, M.; Garnczarska, M. Seed Priming: New Comprehensive Approaches for an Old Empirical Technique. In New Challenges in Seed Biology—Basic and Translational Research Driving Seed Technology; IntechOpen: London, UK, 2016; Chapter 1. [Google Scholar] [CrossRef]
- Baez-Rogelio, A.; Morales-García, Y.E.; Quintero-Hernández, V.; Muñoz-Rojas, J. Next generation of microbial inoculants for agriculture and bioremediation. Microb. Biotechnol. 2016, 10, 19–21. [Google Scholar] [CrossRef]
- Ma, Y. Beneficial Bacteria for Disease Suppression and Plant Growth Promotion. In Plant-Microbe Interactions in Agro-Ecological Perspectives; Springer: Singapore, 2017; pp. 513–529. [Google Scholar] [CrossRef]
- Numan, M.; Bashir, S.; Khan, Y.; Mumtaz, R.; Shinwari, Z.K.; Khan, A.; Khan, A.; Al-Harrasi, A. Plant growth promoting bacteria as an alternative strategy for salt tolerance in plants: A review. Microbiol. Res. 2018, 209, 21–32. [Google Scholar] [CrossRef]
- Allagulova, C.R.; Lastochkina, O.V. Alleviation of drought-induced oxidative stress in wheat plants under the influence of endophytic bacteria—Review. Ecobiotech 2020, 3, 129–134. [Google Scholar]
- Lastochkina, O.; Pusenkova, L.; Yuldashev, R.; Babaev, M.; Garipova, S.; Blagova, D.; Khairullin, R.; Aliniaeifard, S. Effects of Bacillus subtilis on some physiological and biochemical parameters of Triticum aestivum L. (wheat) under salinity. Plant Physiol. Biochem. 2017, 121, 80–88. [Google Scholar] [CrossRef]
- Pandey, P.K.; Singh, M.C.; Singh, S.; Singh, A.K.; Kumar, M.; Pathak, M.; Shakywar, R.C.; Pandey, A.K. Inside the Plants: Endophytic Bacteria and their Functional Attributes for Plant Growth Promotion. Int. J. Curr. Microbiol. Appl. Sci. 2017, 6, 11–21. [Google Scholar] [CrossRef]
- Van Loon, L.C. Plant responses to plant growth-promoting rhizobacteria. Eur. J. Plant Pathol. 2007, 119, 243–254. [Google Scholar] [CrossRef]
- Niu, D.-D.; Liu, H.-X.; Jiang, C.; Wang, Y.-P.; Wang, Q.-Y.; Jin, H.-L.; Guo, J. The Plant Growth–Promoting Rhizobacterium Bacillus cereus AR156 Induces Systemic Resistance in Arabidopsis thaliana by Simultaneously Activating Salicylate- and Jasmonate/Ethylene-Dependent Signaling Pathways. Mol. Plant Microb. Inter. 2011, 24, 533–542. [Google Scholar] [CrossRef]
- Garcia-Gutierrez, L.; Zeriouh, H.; Romero, D.; Cubero, J.; Vicente, A.; Perez-Garcia, A. The antagonistic strain Bacillus subtilis UMAF6639 also confers protection to melon plants against cucurbit powdery mildew by activation of jasmonate- and salicylic acid-dependent defense responses. Microb. Biotech. 2013, 6, 264–274. [Google Scholar] [CrossRef]
- Saikia, J.; Sarma, R.K.; Dhandia, R.; Yadav, A.; Bharali, R.; Gupta, V.K.; Saikia, R. Alleviation of drought stress in pulse crops with ACC deaminase producing rhizobacteria isolated from acidic soil of Northeast India. Sci. Rep. 2018, 8, 3560. [Google Scholar] [CrossRef] [PubMed]
- Lastochkina, O. Bacillus Subtilis-Mediated Abiotic Stress Tolerance in Plants. In Bacilli and Agrobiotechnology: Phytostimulation and Biocontrol; Islam, M.T., Rahman, M.M., Pandey, P., Boehme, M.H., Haesaert, G., Eds.; Springer Nature: Cham, Switzerland, 2019; Volume 2, Chapter 6; pp. 97–133. [Google Scholar]
- Madry, W.; Paderwski Gozdowski, D.; Rozbici, J.; Golba, J.; Piechociński, M.; Studnicki, M.; Derejko, A. Adaptation of winter wheat cultivars to crop managements and Polish agricultural environments. Turk. J. Field Crops 2013, 18, 118–127. [Google Scholar]
- Volis, S.; Ormanbekova, D.; Yermekbayev, K.; Song, M.; Shulgina, I. Multi-approaches analysis reveals local adaptation in the emmer wheat (Triticum dicoccoides) at macro- but not microgeographical scale. PLoS ONE 2015, 10, e0125258. [Google Scholar] [CrossRef]
- Lastochkina, O.V.; Yuldashev, R.A.; Pusenkova, L.I. The effect of bacteria Bacillus subtilis 26D on drought resistance of soft spring wheat cultivars of the West Siberian forest-steppe and Volga steppe ecotypes in the early stages of ontogenesis. Proc. RAS Ufa Sci. Centre 2017, 3, 99–102. [Google Scholar]
- Zhukovsky, P.M. Wheat in the USSR; State Publishing House of Agricultural Literature: Moscow/Leningrad, Russia, 1957; p. 632. [Google Scholar]
- Yakubciner, M.M. Botanical Characteristic of Wheat. Wheat of USSR; Jukovsky, P.M., Ed.; Selkhozizd: Moscow/Leningrad, Russia, 1957; p. 632. [Google Scholar]
- Cigankov, V.I. Development of spring wheat cultivars adaptive to drought steppe regions of Kazakhstan. Proc. Orenbg. State Agr. Univ. 2012, 4, 112–115. [Google Scholar]
- Muhitov, L.A.; Samuilov, F.D. Drought tolerance of different ecotypes of wheat in Forest-Steppe of Orenburg Pre-Ural. Proc. Kazan. State Agric. Univ. 2007, 1, 57–59. [Google Scholar]
- Netrusov, A.I.; Egorova, M.A.; Zakharchuk, L.M. Praktikum po Mikrobiologii (A Practical Course in Microbiology); Izdat. Tsentr Akademiya: Moscow, Russia, 2005; 608p. [Google Scholar]
- Mokronosova, A.T. Small Workshop on Plant Physiology; Moscow State University: Moscow, Russia, 1994; 184p. [Google Scholar]
- Udovenko, G.V. Diagnostics of Plant Tolerance to Stresses: Methodology; VIR: Leningrad, Russia, 1988; 227p. [Google Scholar]
- Jeffrey, S.; Humphrey, G. New spectrophotometric equations for determining chlorophylls a, b, c1 and c2 in higher plants, algae and natural phytoplankton. Biochem. Physiol. Pfl. 1975, 167, 191–194. [Google Scholar] [CrossRef]
- Shchukin, V.B.; Gromov, A.A. Plant Physiology Workshops 2; OSAU Publishing Center: Orenburg, Russia, 2008; 176p. [Google Scholar]
- Bates, L.S.; Waldren, R.P.; Teare, I.D. Rapid determination of free proline for water-stress studies. Plant Soil 1973, 39, 205–207. [Google Scholar] [CrossRef]
- Kalinkina, L.G. Proline accumulation in cells of marine and freshwater chlorella in depending on the concentration of NaCl in the medium and the growth rate of algae. Plant Physiol. 1985, 32, 42–52. [Google Scholar]
- Allagulova, C.R.; Maslennikova, D.R.; Avalbaev, A.M.; Fedorova, K.A.; Yuldashev, R.A.; Shakirova, F.M. Influence of 24-epibrassinolide on growth of wheat plants and the content of dehydrins under cadmium stress. Russ. J. Plant Physiol. 2015, 62, 465–471. [Google Scholar] [CrossRef]
- Temerdashev, Z.; Frolova, N.A.; Kolychev, I.A. Determination of phenolic compounds in medicinal herbs by reversed-phase HPLC. J. Anal. Chem. 2011, 66, 407–414. [Google Scholar] [CrossRef]
- Singh, S.; Singh, U.B.; Malaviya, D.; Paul, S.; Sahu, P.K.; Trivedi, M.; Paul, D.; Saxena, A.K. Seed Biopriming with Microbial Inoculant Triggers Local and Systemic Defense Responses against Rhizoctonia solani Causing Banded Leaf and Sheath Blight in Maize (Zea mays L.). Int. J. Environ. Res. Public Health 2020, 17, 1396. [Google Scholar] [CrossRef]
- Singh, R.P.; Jha, P.; Jha, P.N. The plant-growth-promoting bacterium Klebsiella sp. SBP-8 confers induced systemic tolerance in wheat (Triticum aestivum) under salt stress. J. Plant Physiol. 2015, 184, 57–67. [Google Scholar] [CrossRef]
- Ishak, Z.; Mohd Iswadi, M.K.; Russman Nizam, A.H.; Ahmad Kamil, M.J.; Ernie Eileen, R.R.; Wan Syaidatul, A.; Ainon, H. Plant growth hormones produced by endophytic Bacillus subtilis strain LKM-BK isolated from cocoa. Malays. Cocoa J. 2016, 9, 127–133. [Google Scholar]
- Egamberdieva, D.; Wirth, S.J.; Alqarawi, A.A.; Abd Allah, E.F.; Hashem, A. Phytohormones and beneficial microbes: Essential components for plants to balance stress and fitness. FMC 2017, 8, 2104. [Google Scholar] [CrossRef]
- Çakmakçı, R.; Turan, M.; Kıtır, N.; Güneş, A.; Nikerel, E.; Özdemir, B.S.; Yıldırım, E.; Olgun, M.; Topçuoğlu, B.; Tüfenkçi, Ş.; et al. The Role of Soil Beneficial Bacteria in Wheat Production: A Review. In Wheat Improvement, Management and Utilization; IntechOpen: London, UK, 2017; pp. 115–149. [Google Scholar]
- Díaz-Zorita, M.; Fernández-Canigia, M.V. Field performance of a liquid formulation of Azospirillum brasilense on dryland wheat productivity. Eur. J. Soil Biol. 2009, 45, 3–11. [Google Scholar] [CrossRef]
- Lawlor, D.W.; Tezara, W. Causes of decreased photosynthetic rate and metabolic capacity in water-deficient leaf cells: A critical evaluation of mechanisms and integration of processes. Ann. Bot. 2009, 103, 561–579. [Google Scholar] [CrossRef]
- Yang, P.-M.; Huang, Q.-C.; Qin, G.-Y.; Zhao, S.-P.; Zhou, J.G. Different drought-stress responses in photosynthesis and reactive oxygen metabolism between autotetraploid and diploid rice. Photosynthetica 2014, 52, 193–202. [Google Scholar] [CrossRef]
- Zhang, W.; Xie, Z.; Zhang, X.; Lang, D.; Zhang, X. Growth-promoting bacteria alleviates drought stress of G. uralensis through improving photosynthesis characteristics and water status. J. Plant Interact. 2019, 14, 580–589. [Google Scholar] [CrossRef]
- Zhang, Y.J.; Zhang, Y.; Wang, Y.J.; Su, P.X.; An, L.P.; Gao, H. Effect of water stress on leaf photosynthesis, chlorophyll content, and growth of oriental lily. Russ. J. Plant Physiol. 2011, 58, 844–850. [Google Scholar] [CrossRef]
- Shukla, N.; Awasthi, R.; Rawat, L.; Kumar, J. Biochemical and physiological responses of rice (Oryza sativa L.) as influenced by Trichoderma harzianum under drought stress. Plant Physiol. Biochem. 2012, 54, 78–88. [Google Scholar] [CrossRef] [PubMed]
- Yan, L.; Zou, Y.N.; Wu, Q.S. Effects of Diversispora spurca inoculation on growth, root system architecture and chlorophyll contents of four citrus genotypes. Int. J. Agric. Biol. 2013, 15, 342–346. [Google Scholar]
- Guler, N.S.; Pehlivan, N.; Karaoglu, S.A.; Guzel, S.; Bozdeveci, A. Trichoderma atroviride ID20G inoculation ameliorates drought stress-induced damages by improving antioxidant defence in maize seedlings. Acta Physiol. Plant. 2016, 38, 1–9. [Google Scholar] [CrossRef]
- Takahashi, S.; Murata, N. How do environmental stresses accelerate photoinhibition? Trends Plant Sci. 2008, 13, 178–182. [Google Scholar] [CrossRef]
- Zia, R.; Nawaz, M.S.; Siddique, M.J.; Hakim, S.; Imran, A. Plant survival under drought stress: Implications, adaptive responses, and integrated rhizosphere management strategy for stress mitigation. Microbiol. Res. 2021, 242, 126626. [Google Scholar] [CrossRef]
- Ullah, A.; Sun, H.; Yang, X.; Zhang, X. Drought coping strategies in cotton: Increased crop per drop. Plant Biotechnol. J. 2017, 15, 271–284. [Google Scholar] [CrossRef]
- Barka, E.A.; Nowak, J.; Clément, C. Enhancement of Chilling Resistance of Inoculated Grapevine Plantlets with a Plant Growth-Promoting Rhizobacterium, Burkholderia phytofirmans Strain PsJN. Appl. Environ. Microbiol. 2006, 72, 7246–7252. [Google Scholar] [CrossRef]
- Kiani, S.P.; Talia, P.M.; Maury, P.; Grieu, P.; Heinz, R.; Perrault, A.; Nishinakamasu, V.; Hopp, E.; Gentzbittel, L.; Paniego, N.B.; et al. Genetic analysis of plant water status and osmotic adjustment in recombinant inbred lines of sunflower under two water treatments. Plant Sci. 2007, 172, 773–787. [Google Scholar] [CrossRef]
- Valentovic, P.; Luxova, M.; Kolarovic, L.; Gasparikova, O. Effect of osmotic stress on compatible solutes content, membrane stability and water relations in two maize cultivars. Plant Soil Environ. 2006, 52, 186–191. [Google Scholar] [CrossRef]
- Hare, P.D.; Cress, W.A.; Van Staden, J. Dissecting the roles of osmolyte accumulation in plants. Plant Cell Environ. 1998, 21, 535–553. [Google Scholar] [CrossRef]
- Vardharajula, S.; Zulfikar, A.S.; Grover, M.; Reddy, G.; Bandi, V. Drought-tolerant plant growth promoting Bacillus spp., effect on growth, osmolytes, and antioxidant status of maize under drought stress. J. Plant Interact. 2011, 6, 1–14. [Google Scholar]
- Yoshiba, Y.; Kiyosue, T.; Nakashima, K.; Yamaguchi-Shinozaki, K.; Shinozaki, K. Regulation of levels of proline as an osmolyte in plants under water stress. Plant Cell Physiol. 1997, 38, 1095–1102. [Google Scholar] [CrossRef]
- Chen, K.; Kurgan, L.; Rahbari, M. Prediction of protein crystallization using collocation of amino acid pairs. Biochem. Biophys. Res. Commun. 2007, 355, 764–769. [Google Scholar] [CrossRef]
- Khan, A.L.; Waqas, M.; Kang, S.-M.; Al-Harrasi, A.; Hussain, J.; Al-Rawahi, A.; Al-Khiziri, S.; Ullah, I.; Ali, L.; Jung, H.-Y.; et al. Bacterial endophyte Sphingomonas sp. LK11 produces gibberellins and IAA and promotes tomato plant growth. J. Microbiol. 2014, 52, 689–695. [Google Scholar] [CrossRef]
- Asaf, S.; Khan, A.L.; Khan, M.A.; Imran, Q.M.; Yun, B.-W.; Lee, I.-J. Osmoprotective functions conferred to soybean plants via inoculation with Sphingomonas sp. LK11 and exogenous trehalose. Microbiol. Res. 2017, 205, 135–145. [Google Scholar] [CrossRef]
- Shahzad, R.; Khan, A.L.; Bilal, S.; Waqas, M.; Kang, S.-M.; Lee, I.-J. Inoculation of abscisic acid-producing endophytic bacteria enhances salinity stress tolerance in Oryza sativa. Environ. Exp. Bot. 2017, 136, 68–77. [Google Scholar] [CrossRef]
- Sivanesan, I.; Nair, S. Stress adaptations in a Plant Growth Promoting Rhizobacterium (PGPR) with increasing salinity in the coastal agricultural soils. J. Basic Microbiol. 2008, 48, 378–384. [Google Scholar]
- Nounjan, N.; Chansongkrow, P.; Charoensawan, V.; Siangliw, J.L.; Toojinda, T.; Chadchawan, S.; Theerakulpisut, P. High Performance of Photosynthesis and Osmotic Adjustment Are Associated with Salt Tolerance Ability in Rice Carrying Drought Tolerance QTL: Physiological and Co-expression Network Analysis. Front. Plant Sci. 2018, 9, 1135. [Google Scholar] [CrossRef]
- Sack, L.; Tyree, M.T. Leaf Hydraulics and Its Implications in Plant Structure and Function. In Vascular Transport in Plants; Elsevier: Oxford, UK, 2005; pp. 93–114. [Google Scholar]
- Blackman, C.J.; Brodribb, T.J.; Brodribb, T.J. Two measures of leaf capacitance: Insights into the water transport pathway and hydraulic conductance in leaves. Funct. Plant Biol. 2011, 38, 118. [Google Scholar] [CrossRef]
- Van Meeteren, U.; Aliniaeifard, S. Stomata and Postharvest Physiology. In Book Innovations in Postharvest Technology Series; Pareek, S., Ed.; CRC Press: Boca Raton, FL, USA, 2016; Chapter 6; pp. 157–216. [Google Scholar]
- Choudhary, D.K.; Johri, B.N. Interactions of Bacillus spp. and plants—With special reference to induced systemic resistance (ISR). Microbiol. Res. 2009, 164, 493–513. [Google Scholar] [CrossRef] [PubMed]
- Sayed, S.A.; Atef, A.S.; Soha, E. Response of three sweet basil cultivars to inoculation with Bacillus subtilis and arbuscular mycorrhizal fungi under salt stress conditions. Nat. Sci. 2011, 9, 31–36. [Google Scholar]
- Shakirova, F.M.; Sakhabutdinova, A.R.; Bezrukova, M.; Fatkhutdinova, R.A.; Fatkhutdinova, D.R. Changes in the hormonal status of wheat seedlings induced by salicylic acid and salinity. Plant Sci. 2003, 164, 317–322. [Google Scholar] [CrossRef]
- Shakirova, F.M.; Avalbaev, A.M.; Bezrukova, M.V.; Fatkhutdinova, R.A.; Maslennikova, D.R.; Yuldashev, R.A.; Allagulova, C.R.; Lastochkina, O.V. Hormonal Intermediates in the Protective Action of Exogenous Phytohormones in Wheat Plants Under Salinity: A Case Study on Wheat. In Phytohormones and Abiotic Stress Tolerance in Plants; Khan, N., Nazar, R., Iqbal, N., Anjum, N., Eds.; Springer: Berlin, Germany, 2012; pp. 185–228. [Google Scholar]
- Singh, U.P.; Sarma, B.K.; Singh, D.P. Effect of Plant Growth-Promoting Rhizobacteria and Culture Filtrate of Sclerotium rolfsii on Phenolic and Salicylic Acid Contents in Chickpea (Cicer arietinum). Curr. Microbiol. 2003, 46, 131–140. [Google Scholar] [CrossRef] [PubMed]
- Vlot, A.C.; Dempsey, D.A.; Klessig, D.F. Salicylic Acid, a Multifaceted Hormone to Combat Disease. Annu. Rev. Phytopathol. 2009, 47, 177–206. [Google Scholar] [CrossRef]
- Wu, L.; Huang, Z.; Li, X.; Ma, L.; Gu, Q.; Wu, H.; Liu, J.; Borriss, R.; Wu, Z.; Gao, X. Stomatal Closure and SA-, JA/ET-Signaling Pathways Are Essential for Bacillus amyloliquefaciens FZB42 to Restrict Leaf Disease Caused by Phytophthora nicotianae in Nicotiana benthamiana. Front. Microbiol. 2018, 9, 847. [Google Scholar] [CrossRef]
- Horváth, E.; Szalai, G.; Janda, T. Induction of Abiotic Stress Tolerance by Salicylic Acid Signaling. J. Plant Growth Regul. 2007, 26, 290–300. [Google Scholar] [CrossRef]
- Maruri-López, I.; Aviles-Baltazar, N.Y.; Buchala, A.; Serrano, M. Intra and Extracellular Journey of the Phytohormone Salicylic Acid. Front. Plant Sci. 2019, 10, 423. [Google Scholar] [CrossRef]

Publisher’s Note: MDPI stays neutral with regard to jurisdictional claims in published maps and institutional affiliations. |
© 2020 by the authors. Licensee MDPI, Basel, Switzerland. This article is an open access article distributed under the terms and conditions of the Creative Commons Attribution (CC BY) license (http://creativecommons.org/licenses/by/4.0/).
Share and Cite
Lastochkina, O.; Garshina, D.; Ivanov, S.; Yuldashev, R.; Khafizova, R.; Allagulova, C.; Fedorova, K.; Avalbaev, A.; Maslennikova, D.; Bosacchi, M. Seed Priming with Endophytic Bacillus subtilis Modulates Physiological Responses of Two Different Triticum aestivum L. Cultivars under Drought Stress. Plants 2020, 9, 1810. https://doi.org/10.3390/plants9121810
Lastochkina O, Garshina D, Ivanov S, Yuldashev R, Khafizova R, Allagulova C, Fedorova K, Avalbaev A, Maslennikova D, Bosacchi M. Seed Priming with Endophytic Bacillus subtilis Modulates Physiological Responses of Two Different Triticum aestivum L. Cultivars under Drought Stress. Plants. 2020; 9(12):1810. https://doi.org/10.3390/plants9121810
Chicago/Turabian StyleLastochkina, Oksana, Darya Garshina, Sergey Ivanov, Ruslan Yuldashev, Regina Khafizova, Chulpan Allagulova, Kristina Fedorova, Azamat Avalbaev, Dilara Maslennikova, and Massimo Bosacchi. 2020. "Seed Priming with Endophytic Bacillus subtilis Modulates Physiological Responses of Two Different Triticum aestivum L. Cultivars under Drought Stress" Plants 9, no. 12: 1810. https://doi.org/10.3390/plants9121810
APA StyleLastochkina, O., Garshina, D., Ivanov, S., Yuldashev, R., Khafizova, R., Allagulova, C., Fedorova, K., Avalbaev, A., Maslennikova, D., & Bosacchi, M. (2020). Seed Priming with Endophytic Bacillus subtilis Modulates Physiological Responses of Two Different Triticum aestivum L. Cultivars under Drought Stress. Plants, 9(12), 1810. https://doi.org/10.3390/plants9121810

